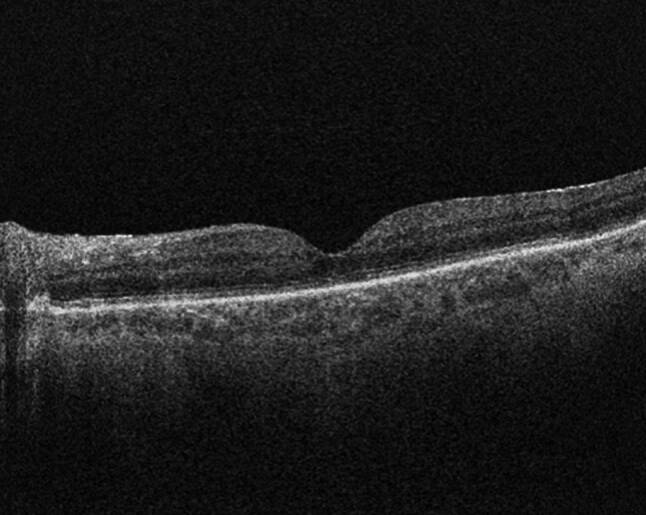

孔源性视网膜脱离的回顾:过去,现在和未来。
IF 1.5
Q2 MEDICINE, GENERAL & INTERNAL
Wiener medizinische Wochenschrift
Pub Date : 2025-05-01
Epub Date: 2025-04-04
DOI:10.1007/s10354-025-01085-9
引用次数: 0
摘要
如果不及时治疗,视网膜脱离有可能成为永久性致盲疾病,因此是眼科紧急情况。这篇综述将概述历史,发病机制,临床表现,以及目前和未来的处理视网膜脱离。本文章由计算机程序翻译,如有差异,请以英文原文为准。

A review of rhegmatogenous retinal detachment: past, present and future.
Retinal detachments are ophthalmic emergencies given their potential to become a permanently blinding disorder if left untreated. This review will outline the history, pathogenesis, clinical presentation, and current and future management of retinal detachments.
求助全文
通过发布文献求助,成功后即可免费获取论文全文。
去求助
来源期刊

Wiener medizinische Wochenschrift
MEDICINE, GENERAL & INTERNAL-
CiteScore
2.50
自引率
0.00%
发文量
79
期刊介绍:
''From the microscope to clinical application!'', Scientists from all European countries make available their recent research results and practical experience through Wiener Medizinische Wochenschrift, the renowned English- and German-language forum. Both original articles and reviews on a broad spectrum of clinical and preclinical medicine are presented within the successful framework of thematic issues compiled by guest editors. Selected cutting-edge topics, such as dementia, geriatric oncology, Helicobacter pylori and phytomedicine make the journal a mandatory source of information.
 求助内容:
求助内容: 应助结果提醒方式:
应助结果提醒方式:


